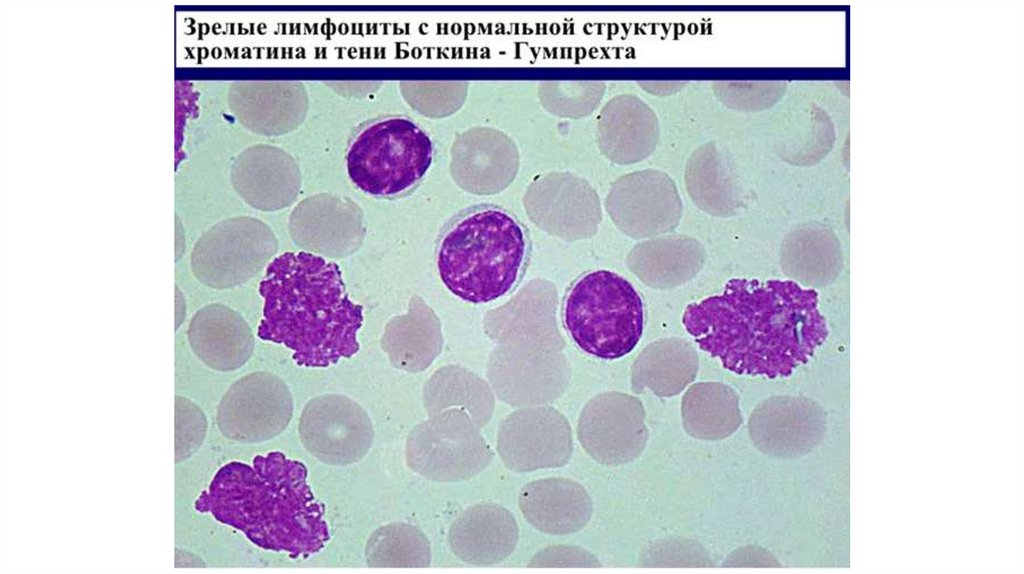

Похожие презентации:
Лейкозы и родственные гемобластозы
1.
2. Гемобластозы. Лейкемоидные реакции. Миелодиспластические синдромы. Лейкозы.
3. Общие характеристики гемобластозов
• Это опухоли кроветворной ткани (затрагивают миело- илимфопоэз)
• В связи с тем, что их нормальные прототипы мигрируют по
организму, опухоли первично метастазируют, т.е. они все
клинически ведут себя как злокачественные опухоли
• Некоторую аналогию между «добром и злом» можно провести с
острыми (более злокачественны, т.к. из бластных клеток) и
хроническими лейкозами (менее злокачественны, т.к. из зрелых
клеток), а также лимфомами из незрелых или зрелых клеток
4. Лейкемоидная реакция
• Это временное значительное увеличение числа лейкоцитов в ответ накакой-либо раздражитель (как правило, выраженный воспалительный
процесс), сопровождающееся появлением в крови незрелых форм
лейкоцитов.
• Имитируют лейкозы
Классификация:
• Миелоидного типа
• с картиной крови, характерной для хронического миелолейкоза
(нейтрофильный лейкоцитоз)
• эозинофильного типа (эозинофильный лейкоцитоз)
• миелобластного типа («псевдобластная», резко выраженный сдвиг влево с
появлением единичных бластов)
• Лимфоидного и лимфомоноцитарного типов (например,
инфекционный мононуклеоз)
• Смешанные
5. Отличия лейкемоидных реакций от лейкозов
• Можно четко определить воспалительную этиологию реакции• Отсутствие клинико-лабораторных признаков изменения
(усиление/ослабление) нормального гемопоэза
• Наличие ядерного сдвига влево
• Токсическая зернистость нейтрофилов
• Отсутствие признаков лейкозов:
• Лейкемический провал
• Эозинофильно-базофильная ассоциация
• Тени Боткина-Гумпрехта
• Экстрамедуллярная (внекостномозговая) пролиферация клеток крови и
резкое увеличение селезенки
• Филадельфийская хромосома
6. Миелодиспластические синдромы –
Это группы клональных нарушений стволовых клеток,характеризующиеся дефектами, ассоциированными с
неэффективным гемопоэзом и высоким риском трансформации в
острый миелолейкоз.
При миелодиспластических синдромах костный мозг частично или
полностью замещается клональными потомками неопластической
стволовой клетки, которые сохраняют способность к
дифференцировке, однако дифференцировка неэффективна или
происходит беспорядочно. Эти клетки остаются в костном мозге, и
у пациента в периферической крови наблюдается цитопения.
7. Миелодиспластические синдромы:
• Первичные• Вторичные (после химиотерапии)
Основные морфологические проявления:
• Эритроциты: кольцевидные сидеробласты, эритробласты с
нагруженными железом митохондриями, мегалобластное
созревание, аномалии ядерного почкования
• Нейтрофилы: сниженное количество вторичных гранул,
токсичные гранулы и/или тельца Деле. Наблюдаются
псевдоклетки Пельгера-Хюэта (нейтрофилы с двумя ядерными
сегментами)
• Мегакариоциты: однодольчатое ядро или множественные ядра
8.
Кумар, Аббас, Фаусто, Астер, перевод с англ. Коган Е.А., 20149.
Лейкоз – опухоль кроветворной системы,первично поражающая клетки костного
мозга.
10. Острые лейкозы VS хронические лейкозы
ПризнакОстрый лейкоз
Хронический лейкоз
Уровень блока дифференцировки
(преобладание опухолевых клеток)
Высокий (на уровне бластных клеток
с их преобладанием)
Низкий (на уровне созревающих
клеток с их преобладанием)
Замещение костного мозга
опухолевым клоном: анемия,
тромбоцитопения, уменьшение
количества нормальных лейкоцитов
Выражено
Выражено на поздних стадиях
Лейкемический провал
Острый миелолейкоз
Нет
Тени Боткина-Гумпрехта
Нет
Хронический лимфолейкоз
Эозинофильно-базофильная
ассоциация
Нет
При хроническом миелолейкозе
Филадельфийская хромосома (Ph,
ген bcr-abl)
Острый лимфолейкоз
Хронический миелолейкоз
Гепатоспленомегалия
Нет (не успевает развиться)
Выражены: гепатоспленомегалия преимущественно при
миелолейкозе, лимфаденопатия при лимфолейкозе
11.
Лейкемический провалколичество
бласты
промиело
циты
миелоциты
метамиело
циты
палочкоядерные
сегментоядерные
уровень
дифференцировки
12.
Острые лейкозы всегда БЛАСТНЫЕХронические лейкозы всегда ЦИТАРНЫЕ
И никак иначе!!!
13.
14. FAB-классификация острых миелолейкозов (острых нелимфобластных лейкозов (ANLL) (1976 г.)
• М0 — острый миелобластный лейкоз с минимальной миелоидной дифференцировкой• М1 — острый миелобластный лейкоз без созревания
• М2 — острый миелобластный лейкоз с созреванием.
• М3 — острый промиелоцитарный лейкоз
• М4 — острый миеломонобластный лейкоз
• М5 — острый монобластный лейкоз
• М6 — острый эритромиелоз
• М7 — острый мегакариобластный лейкоз
• Острый панмиелоз с миелофиброзом
• Миелоидная саркома (в т.ч. хлорома)
• Острый лейкоз неясной линии кроветворения/из 2 клеточных линий
15. Электронограмма. Бластная клетка при лейкозе.
препарат кафедры патологической анатомии ПМГМУ им. Сеченова16. Острый лимфобластный лейкоз
По классификации ВОЗ(2000 г.):
• B-лимфобластный
лейкоз/лимфома из клетокпредшественниц
• Т-клеточный
лейкоз/лимфома из клетокпредшественниц
• Агрессивный NK-клеточный
лейкоз
FAB-классификация острых лимфобластных лейкозов
17.
Унитарная теория кроветворения18.
Основные клинические синдромы при острых лейкозах• Синдром иммунодефицита (вторичные инфекции)
• Анемический синдром
• Геморрагический синдром
• Интоксикационный синдром
• Синдром лейкемической пролиферации (лейкозные инфильтраты в
коже и внутренних органах, язвенно-некротические поражения
органов желудочно-кишечного тракта)
19.
20. Головной мозг при остром лейкозе. Окраска гематоксилин и эозин.
Увеличение 200препарат кафедры патологической анатомии ПМГМУ им. Сеченова
21.
Основные причины смерти при острых лейкозах• Присоединение вторичной инфекции
• Геморрагический синдром (кровоизлияния в жизненно
важные органы)
• Лейкемическое поражение внутренних органов (лейкозный
пневмонит, нейролейкоз, язвенно-некротические поражения
ЖКТ с дальнейшим развитием кровотечения)
22. Хронические миелопролиферативные заболевания
• Истинная полицитемия• Хронический миелолейкоз
• Хронический нейтрофильный лейкоз
• Хронический эозинофильный лейкоз
• Хронический идиопатический миелофиброз
• Эссенциальная тромбоцитемия
• Неклассифицируемые заболевания
23. Различия некоторых миелопролиферативных заболеваний
ЗаболеваниеЭритроц
иты
Лейкоц
иты
Тромбо
циты
Миело
фиброз
Спленоме ЩФ
галия
лейкоцито
в
Ph-хромосома
Истинная
полицитемия
+++
++
++
+/-
+
Повыш.
Нет
Эссенциальная
тромбоцитемия
+/-
+/-
+++
+/-
+/-
+/-
Нет
Хронический
миелолейкоз
-
+++
+++
+++
+++
Пониж.
Есть
24. Основные характеристики хронического миелолейкоза
• Наличие филадельфийскойхромосомы (ген bcr-abl)
• Наличие эозинофильнобазофильной ассоциации
• Инфильтрация миелоидными
клетками портальных трактов,
синусоидов и центральных вен в
печени
25. Стадии течения хронического миелолейкоза
• Хроническая – бластов 5-10%• Акселерации – бластов 10-19%
• Бластного криза – более 20% бластов в красном
костном мозге и крови; хронический миелолейкоз
превращается в острый миелолейкоз
26.
Пиоидный костный мозг при хроническом миелолейкозеhttp://vmede.org/sait/?page=15&id=Anatomija_patologicheskaja_3airatyan_2010&menu=Anatomija_patologicheskaja_3airatyan_2010
27.
Гепатомегалия при хроническом миелолейкозеhttp://vmede.org/sait/?page=15&id=Anatomija_patologicheskaja_3airatyan_2010&menu=Anatomija_patologicheskaja_3airatyan_2010
28. Печень при хроническом миелоидном лейкозе. Окраска гематоксилин и эозин.
Увеличение 200препарат кафедры патологической анатомии ПМГМУ им. Сеченова
29.
Множественные инфаркты в селезенке30. Нормальная селезенка и селезенка при хроническом миелоидном лейкозе.
31.
32.
Классификация хронических лимфолейкозов (А.И.Воробьев, 1999):По клеточному субстрату:
• В-клеточный вариант
• Т-клеточный вариант
По клиническому течению:
• Доброкачественная форма
• Прогрессирующая форма
• Селезеночная форма
• Абдоминальная форма
• Опухолевая форма
• Костномозговая форма
33.
Брыжеечные лимфоузлы при хроническом лимфолейкозе34.
35.
Нормальный лимфатический узел и узел при хроническом лимфолейкозе.36. Печень при хроническом лимфолейкозе. Окраска гематоксилином и эозином.
Увеличение 100препарат кафедры патологической анатомии ПМГМУ им. Сеченова
37.
38. Истинная полицитемия (эритремия, болезнь Вакеза-Ослера)
Хроническое прогрессирующее клональноемиелопролиферативное заболевание,
характеризующееся гиперпролиферацией
эритроидного, миелоидного и мегакариоцитарного
ростков кроветворения
(Национальное руководство Гематология, 2015)
39. Стадии истинной полицитемии
Стадия I – начальная: повышение содержания гемоглобинаСтадия II – эритремическая:
Фаза А - без миелоидной метаплазии селезенки (простой вариант
плеторы без спленомегалии). Тотальная трех-ростковая гиперплазия
костного мозга. Отсутствие экстрамедуллярного гемопоэза
Фаза Б - с миелоидной метаплазией селезенки. Большой миелопролиферативный синдром: панцитоз в периферической крови, в
костном мозге имеется панмиелоз с очаговым миелофиброзом или без
него, миелоидная метаплазия селезенки с фиброзом или без него
Стадия III – развитие постэритремического миелофиброза (клинически –
панцитопения) или острого лейкоза.
40. Клиническая симптоматика
• Плеторический синдром: эритроцианотическая окраска лица, видимыхслизистых, рук, ногтевых лож
• Артериальная гипертензия
• Гепатомегалия, спленомегалия
• Кожный зуд, усиливающийся при умывании или приеме ванны
• Эритромелалгия – жгучая боль в пальцах, их покраснение и
увеличение местной температуры
• Уратные камни мочевыводящих путей
• Тромбозы различной локализации (вены нижних конечностей, артерии
миокарда, головного мозга, других внутренних органов) – наиболее
частые причины смерти больных эритремией
• Боли в животе (синдром Бадда-Киари, тромбоз мезентериальных вен)

Медицина
Медицина








